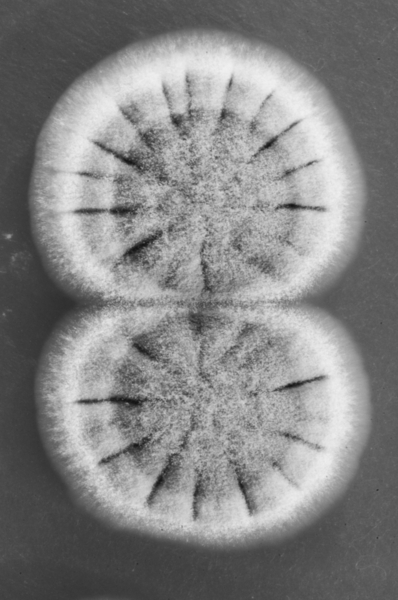
fungi von Jim Occi

fungi - Jim Occi

fungi


Kunstwerk
Künstler:
Kunststil:
Werk:
fungi (2013)
Technik:
digital photography
Bildnummer:
ADW2560269
EAN-Nummer:
4065892153971
Bild
American














